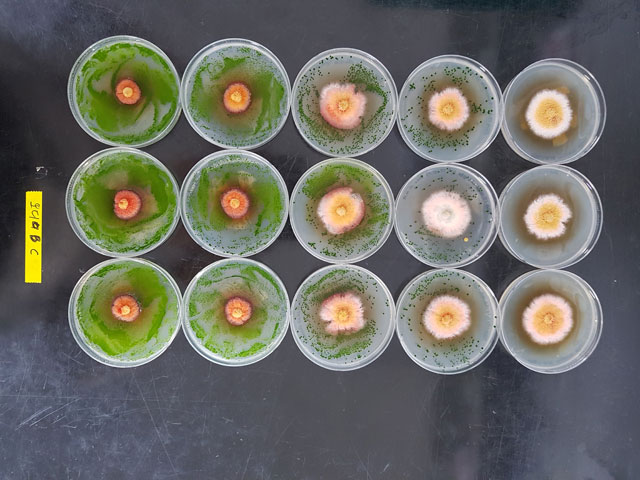

Development of Control Technology against Unpredicted Diseases and Insect Pests
The quick diagnosis of non-native and unpredicted diseases and insect pests and the development of earlier prediction technology
- Production and distribution of earlier diagnosis manuals for vegetables and fruits, and illustrated diseases and insect pests books for small-scale crops
- Development of remote prediction technology against unpredicted insect pests using ICT, and the implementation of an early diagnosis system for diseases and insect pests
Manual for Diagnosis of Diseases and Insect Pests

Prediction on unpredicted diseases and insect pests using ICT

Implementation of diagnosis system against the latest diseases and insect pests
Development of extensive control technology against outstanding diseases and insect pests and distribution of the technology to farmers
- Development of extensive identification and control technology against the occurrence of diseases and insect pests on major economic crops
- Analysis of medicinal effects and toxicity of pesticides on small-scale crops to cope with Positive List System(PLS)

Damage by thermophilic insects

Control technology against southern stem and root rot of sweet potatoes
PLS response test
Implementation of a system to control agricultural environment resources and the use of recyclable resources from farming
- Survey and evaluation of the change in agricultural environment resources
- Development of technology to use recyclable resources and soil improvement for newly reclaimed land
- Soil and agricultural water tests, fertilizer quality control, and evaluation of the safety of farm products

Evaluation on the change of the agricultural environment

Implementation of the system to use recyclable resources

Support for analysis on civil petition
Development of greenhouse gasses reduction, of organic, of organic farming techniques.
- Assessment of greenhouse gas emissions through treating organic agricultural materials
- Development of environmental-friendly organic farming materials, of biological resources utilizing techniques and manual
Greenhouse gas analysis system
Chlorella anti-bacterial effect

Manual on quality control against natural enemies



